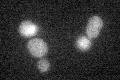
YHR171W
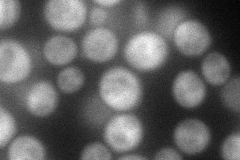
YHR171W
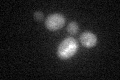
YHR171W

View description
Autophagy-related protein and dual specificity member of the E1 family of ubiquitin-activating enzymes; mediates the conjugation of Atg12p with Atg5p and Atg8p with phosphatidylethanolamine, required steps in autophagosome formation
Localization:
Intensity:
Fold change:
Significance:
-
C’ GFP library in SD
below threshold17.57 -
N' NOP1pr-GFP in SD

cytosol67.0814 -
N' TEF2pr-mCherry in SD
cytosol75.566 -
N' NATIVEpr-GFP in SD

below threshold22.4142 -
N' TEF2pr-VC and Cyto-VN in SD

#N/A0 -
C’ GFP library in SD+DTT
cytosol14.230.8No -
C’ GFP library in SD+H2O2

cytosol14.610.83No -
C’ GFP library in Starvation Media

cytosol14.940.84No -
C’ GFP library on the background of Pup2-DaMP

below threshold -
C’ GFP library on the background of CCT mutant

below threshold15.60940.887846No
